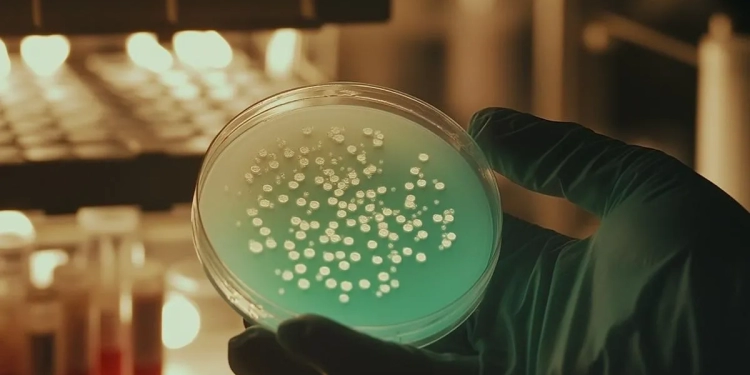

Un paso decisivo en la lucha contra las infecciones hospitalarias
La neumonía adquirida en hospitales (también conocida como neumonía nosocomial) representa uno de los principales desafíos en la atención médica mundial. En el Reino Unido, el Servicio Nacional de Salud (NHS) enfrenta cada año miles de casos que prolongan estancias hospitalarias, aumentan costos y elevan riesgos para los pacientes.
Para enfrentar esta problemática, el grupo británico EDX Medical Group, en colaboración con organismos sanitarios del país, ha desarrollado una prueba diagnóstica rápida que promete identificar casos de neumonía hospitalaria en un tiempo significativamente menor que las técnicas tradicionales.
Velocidad y precisión para salvar vidas
Actualmente, los métodos convencionales de diagnóstico pueden tardar entre 48 y 72 horas en confirmar la presencia de la bacteria u organismo causante. Esto retrasa la administración de un tratamiento específico y, en consecuencia, puede empeorar el pronóstico del paciente.
La nueva tecnología de EDX Medical Group logra detectar la infección en un plazo mucho más corto, lo que permitiría a los médicos iniciar terapias dirigidas casi de inmediato. Esto no solo mejoraría la tasa de recuperación, sino que también reduciría la necesidad de tratamientos antibióticos prolongados, ayudando a combatir la resistencia bacteriana.
Impacto directo en la gestión hospitalaria
Más allá del beneficio clínico, esta prueba podría tener un efecto notable en la gestión de recursos sanitarios. Al acelerar los diagnósticos:
-
Se liberarían camas más rápidamente, permitiendo atender a un mayor número de pacientes.
-
Se optimizarían los tiempos del personal médico, evitando esperas innecesarias en cuidados críticos.
-
Se reducirían los costos asociados a estancias prolongadas y complicaciones derivadas de diagnósticos tardíos.
El NHS, que enfrenta una presión constante por la demanda de camas y servicios, podría ver en esta innovación una herramienta clave para aliviar la carga en hospitales públicos.
Prevención y control de infecciones nosocomiales
La neumonía hospitalaria es parte de un grupo más amplio de infecciones adquiridas en centros de salud, que incluyen infecciones del tracto urinario, bacteriemias y otras enfermedades asociadas al uso de dispositivos invasivos. Cada año, estas infecciones afectan a millones de pacientes en el mundo y su prevención es una prioridad global.
La implementación de pruebas rápidas no solo ayuda en el diagnóstico, sino que también permite reforzar los protocolos de aislamiento y control, reduciendo la propagación de patógenos dentro del hospital.
Potencial aplicación en República Dominicana
Aunque esta innovación se ha desarrollado en el Reino Unido, su potencial para países como la República Dominicana es evidente. En un sistema de salud donde las infecciones hospitalarias también representan un reto, la disponibilidad de herramientas rápidas y accesibles podría transformar la atención médica, mejorando los resultados clínicos y optimizando el uso de recursos.
El test rápido para neumonía hospitalaria de EDX Medical Group representa una oportunidad única para modernizar el diagnóstico en entornos hospitalarios, fortalecer la prevención de infecciones y optimizar la gestión de camas y recursos sanitarios. Si logra expandirse a otros países, podría convertirse en un estándar de oro en la atención médica hospitalaria global.